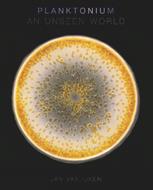

L’articolo è stato aggiunto alla lista dei desideri
IBS.it, l'altro eCommerce
Planktonium: An Unseen World
Cliccando su “Conferma” dichiari che il contenuto da te inserito è conforme alle Condizioni Generali d’Uso del Sito ed alle Linee Guida sui Contenuti Vietati. Puoi rileggere e modificare e successivamente confermare il tuo contenuto. Tra poche ore lo troverai online (in caso contrario verifica la conformità del contenuto alle policy del Sito).
Grazie per la tua recensione!
Tra poche ore la vedrai online (in caso contrario verifica la conformità del testo alle nostre linee guida). Dopo la pubblicazione per te +4 punti
Altre offerte vendute e spedite dai nostri venditori

Tutti i formati ed edizioni
Promo attive (0)
"The new book features a ton of never-before-seen photos that expose the sheer variety, wonder, and beauty of these organisms that inhabit all the waters around us." — Deeper Blue Planktonium is a photo project and a short film by Dutch photographer/cinematographer Jan van Ijken about the unseen world of living microscopic plankton. It is a voyage into a secret universe inhabited by alien-like creatures. These stunningly beautiful, extremely diverse, and numerous organisms are unknown to most of us because they are invisible to the naked eye. However, they are wandering beneath the surface in waters all around us and are of vital importance for all life on earth. Phytoplankton (small plant-like cells) produce half of all the oxygen on earth by photosynthesis, like plants and trees do on land. Zooplankton form the base of the food chain of aquatic life. Plankton also play an important part in the global carbon cycle. They are currently threatened by climate change, global warming and the acidification of the oceans. Jan van Ijken photographed the plankton through microscopes, revealing the beauty and delicate structures of these minute organisms in the finest detail.
L'articolo è stato aggiunto al carrello
Le schede prodotto sono aggiornate in conformità al Regolamento UE 988/2023. Laddove ci fossero taluni dati non disponibili per ragioni indipendenti da IBS, vi informiamo che stiamo compiendo ogni ragionevole sforzo per inserirli. Vi invitiamo a controllare periodicamente il sito www.ibs.it per eventuali novità e aggiornamenti.
Per le vendite di prodotti da terze parti, ciascun venditore si assume la piena e diretta responsabilità per la commercializzazione del prodotto e per la sua conformità al Regolamento UE 988/2023, nonché alle normative nazionali ed europee vigenti.
Per informazioni sulla sicurezza dei prodotti, contattare productsafetyibs@feltrinelli.it
L’articolo è stato aggiunto alla lista dei desideri

